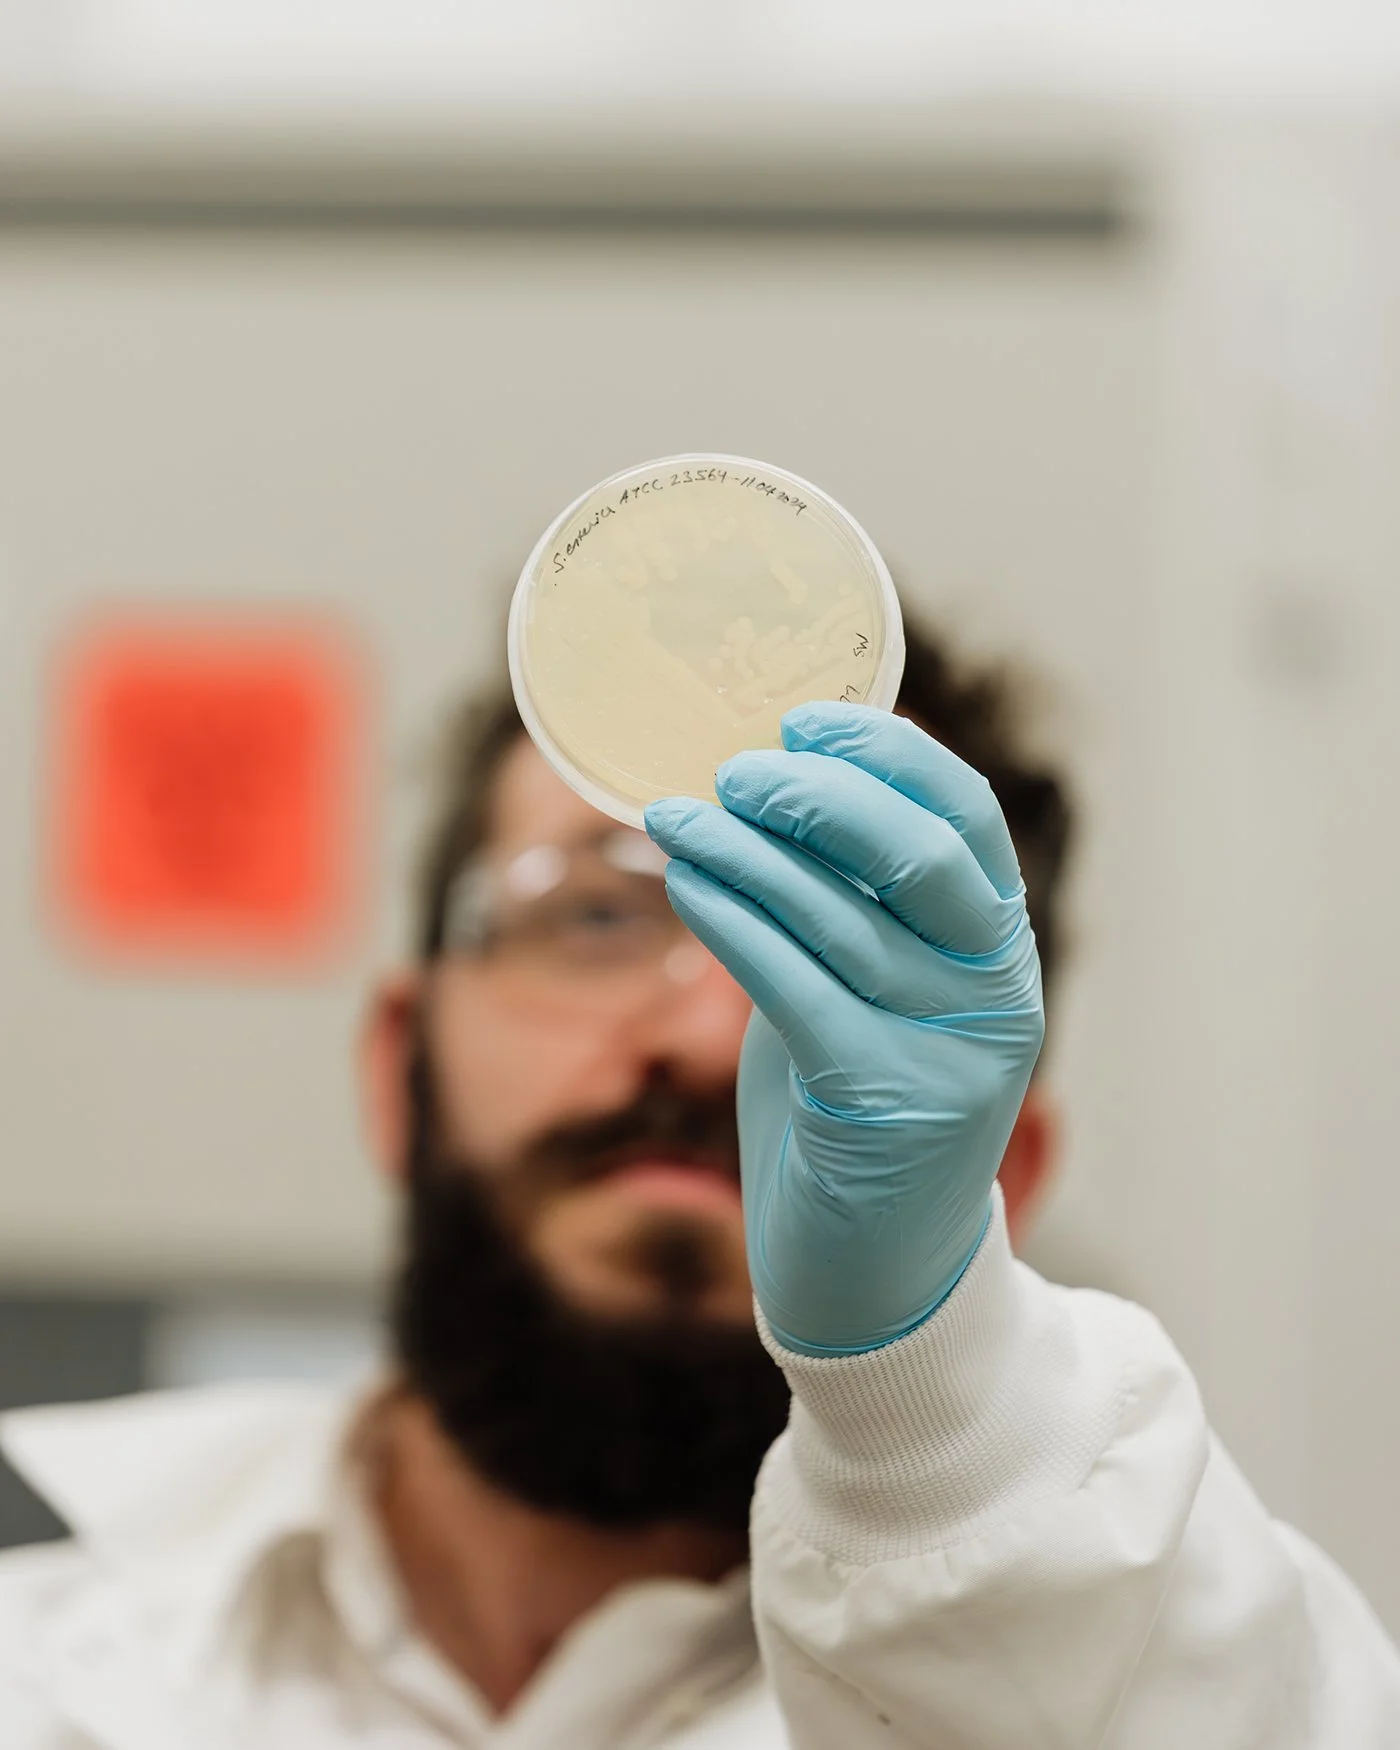

Explore hundreds of opportunities, in a single project.
Test novel ingredients and expand market potential, with customized + tightly controlled research and development.

Validating that your product or innovation can impact specific outcomes can be costly and time consuming, without the right help.
There are dozens of potential outcomes that could differentiate your product from others in the marketplace
The nuance between functional and regulated health claims such as; aquatic safety, nutrition, or dosing requirements, is complex
Moving from bench-top into tank based studies can create a costly bottleneck when using multiple suppliers
Get the data you need to develop a differentiated product, with guidance from the experts at Onda.
Through our bespoke health, nutrition and laboratory services, and a rich library of customizable models we act as your partners in product innovation.


Full-service, in house resources
Our integrated research, laboratory and feed production supports the fast-paced development of competitive products that deliver greater value to the end customer.
Guidance from ideation to production
From discovery, through deployment we help you meet your goals and exceed market expectations, with expert guidance every step of the way.

From bench to tank based studies
Bench-top testing and analysis supports novel product development, and expands market potential for pharmaceutical companies, aquatic producers, and feed manufacturers.

Find the right regulatory pathway
With decades of experience in regulatory compliance, our expert teams help you get on the softest regulatory pathway that aligns with your goals and the relevant global market standards.
Scalable research that fuels innovation across aquaculture.
Fatty Acids
Antimicrobials
Pesticides
Vitamins
Bioactive Peptides
Pre/Probiotics
Making a health treatment product? Click here.
Our world-class facilities and containment certification allow us to work with disease-causing organisms from anywhere in the world.
Characterize the efficacy of a single test product across more than 45 different pathogens including bacteria, viruses, and parasites.
Bespoke bench-top testing allows you to affordably screen candidate products to support moving into tank studies. Tank-based testing pipelines allow you to validate whether your test product(s) have important outcomes for the health of aquaculture.
-
Gut Health
(Palatability, microbiome, inflammation)
-
Disease Tolerance
(Bacteria, viruses, parasites, etc.)
-
Stress Resistance
(Handling, thermal, crowding, environmental)
-
Barrier Health
(Skin, gill and mucus health)
-
Smolt Optimization
(Survival, performance, immunity)
-
Physiological Performance
(Filet quality, aerobic scope, digestibility, metabolism)

Navigating the product maturity + characterization pathway in Aquaculture.
As your partners in product innovation and development, our expert teams support your project at every stage of the process—from ideation to manufacturing—our experts ensure you develop a differentiated product, ready for market.



HEALTH PRODUCT CASE STUDY
Groundbreaking Research Fuels the Introduction of Mycofence®: Advancing Immunity Solutions in Aquaculture
Onda helps Citribel identify an innovative new use for Aspergillus niger mycelium- derived β-glucan, a byproduct of its production process.

You’ve got questions, we can help find the answers.
Get the data you need to develop a differentiated health product, that’s ready for market.








